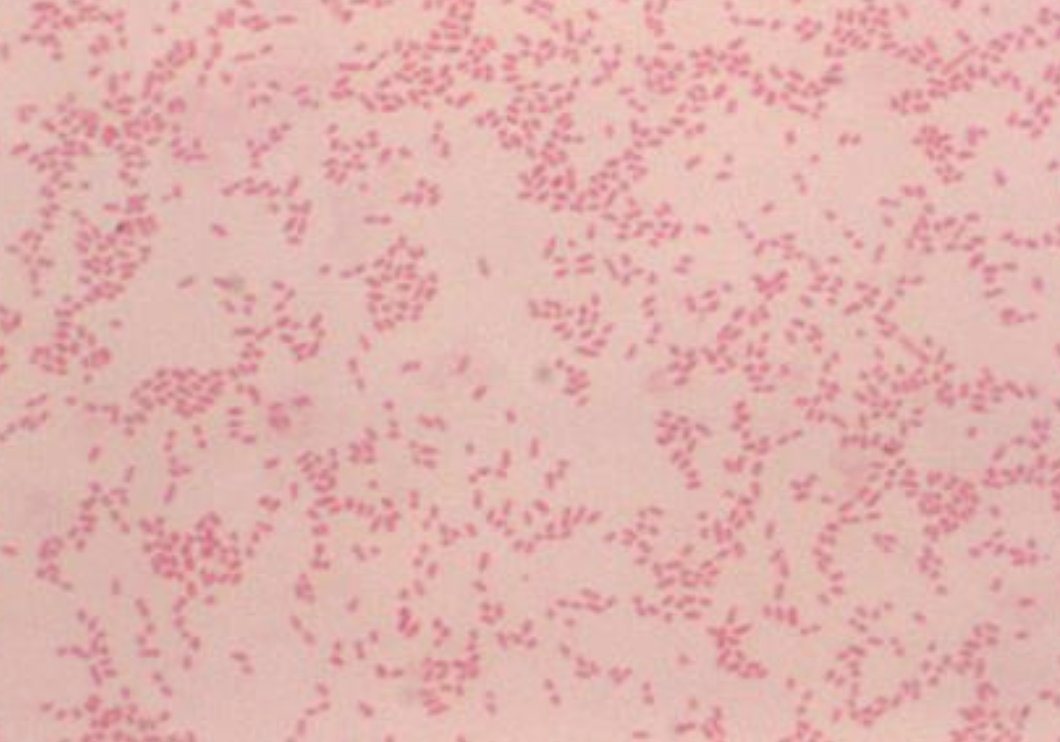
#idboardreview Few household members &amp; veterinary staff got exposed to a pregnant stray dog who later aborted puppies IFA +brucella canis &amp; pcr+vaginal secretions. 2 ppl had direct contact w/dog's placenta without PPE. What abx prophylaxis? #idxposts #idmeded #meded

Hamed Sharaf
@hamed930
Infection Doctor 🦠🦠 | Antibiotic guardian 💉💉 | keen gamer 🎮🎮 | Views are my own 😎😎!!
ID: 393583784
18-10-2011 19:17:15
130 Tweet
123 Followers
179 Following



Hamed Sharaf Louise Sweeney🦄 @antibioticangel

Our EM/global health fellow North Manchester General Hospital on the 12 month combined post in #ID , EM with katherine potier and time to do DTM&H LSTM Great work this year Molly and Naomi 🌍🌎 leann johnson JoB-LadyBaxter


It's been a long time coming but had a great experience working on the Hospital Infection Services National Workforce Survey tinyurl.com/4a2xp7fp with @biainfection RC of Pathologists Dinesh Aggarwal Dave Partridge @SwanseaBug @MartinLlewelyn








Valproate serum concentration 🔽 when co-administered with a carbapenem Clinical Sequelae? 🆕️🔥Retrospective Analysis Open Forum Infectious Diseases In those prescribed valproate for its antiepileptic properties seizures occurred after carbapenem Rx in 46.3% of encounters academic.oup.com/ofid/article/d…